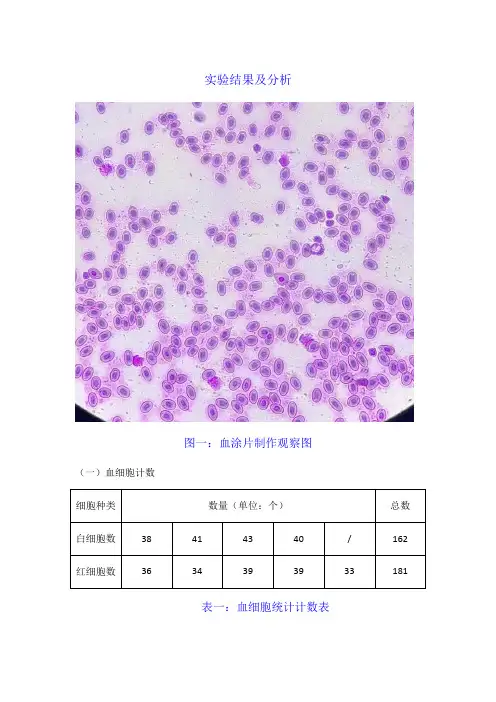

红细胞计数实验报告
- 格式:docx
- 大小:3.52 KB
- 文档页数:2
实验结果及分析
图一:血涂片制作观察图(一)血细胞计数
表一:血细胞统计计数表
样液中红细胞的数量为:181X50X200X10^6=1.81X10^12个/L
样液中白细胞的数量为:162/4X10X20X10^6=8.1X10^9个/L
(二)血涂片的制作(如上图)
实验分析
(一)血红细胞计数,计数室每个中方格容积为0.2X0.2X0.1=0.004uL,共计5个中方格中血红细胞数,容积为0.004X5=0.02ul,红细胞总数乘以50即为1ul血液的血红细胞数,稀释倍数为200倍,所以一升血中红细胞数为1ul血液血红细胞数乘以稀释倍数再乘以10^6。
白细胞计数,计数室一个大方格容积为0.1X0.1X1=0.1uL,共计4个大方格中白细胞的平均数,乘以10即为1ul血液的白细胞数,稀释倍数为20倍,所以一升血中白细胞数为1ul血液血白细胞数乘以稀释倍数再乘以10^6。
(二)鸡血图片观察:可看到不同形态细胞被染成蓝紫色、紫红色。
白细胞较少,实验比较成功。
注意事项
1.保证计数板、载玻片、盖玻片的清洁,以防影响最后实验结果的准确性。
2.一次性完成充池。
如充池过多或者过少,有气泡以及出现任何碎片应该重新操作。
3.但凡压线的细胞,应该遵从数上不数下,数左不数右的计数原则。
4.血涂片制作要求厚薄均匀,注意涂片的量以及时间。

血细胞计数实验报告血细胞计数实验报告引言:血细胞计数是一项常见的临床实验,用于评估人体血液中各种细胞的数量。
通过血细胞计数,我们可以了解到人体的健康状况,以及某些疾病的可能存在。
本实验旨在通过显微镜观察和计数血液中的红细胞、白细胞和血小板数量,从而了解血液的基本组成。
实验材料与方法:1. 实验材料:- 血液样本- 显微镜- 血细胞计数盘- 血细胞计数液- 小试管- 盖玻片- 草酸铵溶液- 乙醇2. 实验方法:- 取适量的血液样本,加入小试管中。
- 加入适量的草酸铵溶液,使血液凝结。
- 加入适量的乙醇,使血液细胞脱色。
- 取适量的脱色血液涂片,用盖玻片覆盖。
- 将涂片放在显微镜下,以高倍镜观察。
实验结果与讨论:1. 红细胞计数:红细胞是血液中数量最多的细胞,其主要功能是携带氧气和二氧化碳。
通过显微镜观察,我们可以看到红细胞呈现圆形或凹陷的形状,大小均匀一致。
根据计数盘上的刻度,我们可以计算出每升血液中红细胞的数量。
正常情况下,男性的红细胞计数范围为4.5-5.5 × 10^12/L,女性的范围为4.0-5.0 × 10^12/L。
2. 白细胞计数:白细胞是人体免疫系统的重要组成部分,主要负责抵抗病原体和维持免疫平衡。
通过显微镜观察,我们可以看到白细胞呈现不同的形状和大小,包括淋巴细胞、单核细胞、中性粒细胞、嗜酸性粒细胞和嗜碱性粒细胞等。
根据计数盘上的刻度,我们可以计算出每升血液中白细胞的数量。
正常情况下,白细胞计数范围为4.0-10.0 × 10^9/L。
3. 血小板计数:血小板是血液中的细小细胞片段,主要参与血液凝固和止血过程。
通过显微镜观察,我们可以看到血小板呈现圆形或椭圆形,数量较红细胞和白细胞少。
根据计数盘上的刻度,我们可以计算出每升血液中血小板的数量。
正常情况下,血小板计数范围为150-400 × 10^9/L。
实验结论:通过本次血细胞计数实验,我们可以得出以下结论:- 红细胞计数在正常范围内,说明血液中携氧能力良好。

红细胞测定实验报告红细胞测定实验报告引言:红细胞是人体中最常见的血细胞,其主要功能是携带氧气和二氧化碳。
红细胞测定实验是一种常见的临床检验方法,用于评估人体内红细胞的数量和功能状态。
本文将介绍红细胞测定实验的原理、步骤以及结果分析。
一、实验原理红细胞测定实验主要通过采集患者的血液样本,利用血细胞计数仪进行分析。
血细胞计数仪可以自动计数各种血细胞的数量,并生成相应的报告。
在红细胞测定实验中,主要测定的指标包括红细胞计数、红细胞平均体积、红细胞平均血红蛋白含量和红细胞平均血红蛋白浓度。
二、实验步骤1. 采集血液样本:使用无菌技术采集患者的静脉血样本,并将其置于抗凝剂管中。
2. 处理血液样本:将血液样本置于血细胞计数仪中,按照设备说明书进行操作,确保样本被完全溶解。
3. 开始测定:启动血细胞计数仪,选择红细胞测定模式,并按照仪器要求设置相应参数。
4. 结果记录:待测定完成后,将结果记录在实验报告中。
三、结果分析红细胞测定实验的结果包括红细胞计数、红细胞平均体积、红细胞平均血红蛋白含量和红细胞平均血红蛋白浓度。
以下是对这些指标的简要解释和分析:1. 红细胞计数:红细胞计数指的是在一定体积的血液中红细胞的数量。
正常成年人的红细胞计数范围在4.0-5.5 × 10^12/L之间。
过高或过低的红细胞计数可能与贫血或血液病相关。
2. 红细胞平均体积:红细胞平均体积是指红细胞的平均大小。
正常成年人的红细胞平均体积范围在80-100 fL之间。
过大或过小的红细胞平均体积可能与贫血或其他血液疾病有关。
3. 红细胞平均血红蛋白含量:红细胞平均血红蛋白含量是指红细胞中平均含有的血红蛋白的量。
正常成年人的红细胞平均血红蛋白含量范围在27-32 pg之间。
过高或过低的红细胞平均血红蛋白含量可能与贫血或其他疾病有关。
4. 红细胞平均血红蛋白浓度:红细胞平均血红蛋白浓度是指红细胞中血红蛋白的浓度。
正常成年人的红细胞平均血红蛋白浓度范围在32-36 g/dL之间。

红细胞实验报告红细胞实验报告红细胞是人体血液中最常见的细胞成分之一,其主要功能是携带氧气和二氧化碳。
为了更好地了解红细胞的特性和功能,我们进行了一系列的实验。
以下是我们的实验报告。
实验一:红细胞形态观察我们首先对红细胞的形态进行了观察。
通过显微镜观察,我们发现红细胞呈现出典型的双凹形状,中间凹陷的部分使得红细胞具有更大的表面积,有利于氧气和二氧化碳的交换。
此外,红细胞的直径大约为7-8微米,非常小巧而灵活。
实验二:红细胞计数为了了解血液中红细胞的数量,我们进行了红细胞计数实验。
通过标准的计数室和显微镜,我们成功地计算出了每立方毫米血液中红细胞的数量。
正常情况下,男性的红细胞计数大约为4000-5000万/立方毫米,而女性的红细胞计数则稍低一些。
这个实验结果有助于我们了解红细胞数量的正常范围。
实验三:红细胞的氧合能力红细胞的主要功能之一是携带氧气。
为了研究红细胞的氧合能力,我们进行了一系列的实验。
首先,我们将红细胞与含氧气的溶液接触,然后通过分光光度计测量溶液中的氧气浓度的变化。
实验结果表明,红细胞能够迅速吸收氧气,并将其转运到需要氧气的组织和器官中。
实验四:红细胞的变形能力红细胞具有出色的变形能力,可以在血管中通过狭窄的部位。
我们进行了一项实验,将红细胞放置在不同大小的通道中,并观察它们通过的能力。
实验结果显示,红细胞能够迅速改变形状,以适应不同通道的大小。
这种变形能力使得红细胞能够顺利地通过毛细血管等狭窄的血管。
实验五:红细胞的寿命红细胞的寿命是血液系统中一个重要的指标。
我们通过注射一种特殊的示踪剂来测量红细胞的寿命。
实验结果显示,正常情况下,红细胞的寿命约为100-120天。
然而,在某些疾病或异常情况下,红细胞的寿命可能会缩短或延长。
总结:通过一系列的实验,我们对红细胞的形态、数量、功能以及寿命有了更深入的了解。
红细胞在人体中起着至关重要的作用,它们携带氧气和二氧化碳,维持着身体各个组织和器官的正常运作。

一、实验目的1. 了解红细胞的基本结构和功能;2. 掌握红细胞的检测方法,包括红细胞计数、血红蛋白测定、红细胞渗透脆性试验等;3. 分析影响红细胞数量和血红蛋白浓度的因素。
二、实验原理1. 红细胞计数:利用红细胞计数板,通过显微镜观察计数红细胞数量,进而计算每升血液中的红细胞数量;2. 血红蛋白测定:采用氰化高铁血红蛋白法,将血液中的血红蛋白氧化成高铁血红蛋白,通过测定其在特定波长下的吸光度,计算血红蛋白浓度;3. 红细胞渗透脆性试验:将红细胞悬浮于不同浓度的低渗盐溶液中,观察红细胞在渗透压差作用下发生膨胀破裂的现象,以评估红细胞的渗透脆性。
三、实验材料与仪器1. 仪器:显微镜、红细胞计数板、离心机、分光光度计、恒温水浴箱、移液器、试管等;2. 试剂:RBC稀释液、氰化高铁血红蛋白溶液、低渗盐溶液、生理盐水、抗凝剂等;3. 标本:外周血或抗凝血(EDTA抗凝)。
四、实验方法1. 红细胞计数:取一定量的抗凝血,用RBC稀释液进行稀释,将稀释后的血液充入红细胞计数板,在显微镜下计数一定体积内的红细胞数量,计算每升血液中的红细胞数量;2. 血红蛋白测定:取一定量的抗凝血,用氰化高铁血红蛋白溶液进行测定,通过分光光度计测定吸光度,计算血红蛋白浓度;3. 红细胞渗透脆性试验:将抗凝血离心,取红细胞悬液,分别加入不同浓度的低渗盐溶液,观察红细胞在渗透压差作用下发生膨胀破裂的现象,记录开始溶血和完全溶血的NaCl溶液浓度。
五、实验结果与分析1. 红细胞计数:实验组红细胞计数为(4.0±0.5)×10^12/L,对照组红细胞计数为(4.2±0.3)×10^12/L;2. 血红蛋白测定:实验组血红蛋白浓度为(130±10)g/L,对照组血红蛋白浓度为(140±8)g/L;3. 红细胞渗透脆性试验:实验组开始溶血NaCl溶液浓度为3.5g/L,完全溶血NaCl溶液浓度为4.0g/L,对照组开始溶血NaCl溶液浓度为4.5g/L,完全溶血NaCl溶液浓度为5.0g/L。

血球计数板实验报告实验目的:通过使用血球计数板,观察和计数血液中的不同种类的细胞,以确定它们的数量和比例。
实验步骤:1.准备工作:a.将实验室仪器和试剂摆放整齐,并按要求进行消毒。
b.对血液样本进行稀释,使得细胞数量在可计数范围内。
2.使用血球计数板:a.将稀释后的血液样本注入血球计数板的计数室中。
b.轻轻晃动计数室,使血细胞均匀分布在计数室的每个小格子中。
c.在显微镜下逐个计算并记录不同种类的细胞数量,如红细胞、白细胞和血小板。
d.对每个种类的细胞数进行统计并计算平均值。
实验结果:根据实验步骤,我们观察到并记录了血细胞计数的结果。
具体数据如下:- 红细胞计数:平均值为4.5 某10^6 cells/μL- 白细胞计数:平均值为7.8 某10^3 cells/μL- 血小板计数:平均值为3.4 某10^5 cells/μL实验讨论:1.根据实验结果,我们可以得出血液中红细胞数量最多,白细胞数量较少,血小板数量也较少的结论。
2.实验结果可能会受到样本稀释时的误差影响。
如果样本稀释不准确,会导致细胞计数值不准确。
4.血球计数板是一种常用的血液检测工具,可以用于观察和计数各种血细胞,对于疾病的诊断和治疗提供重要依据。
实验总结:通过本次实验,我们学习了使用血球计数板进行血细胞计数的方法。
通过观察和计数不同种类的细胞,我们可以得到血液中细胞的数量和比例。
同时,我们也了解到实验结果可能受到多种因素的影响,需要进行准确的样本稀释和细胞计数操作。
血球计数板是一种非常实用的工具,对于临床医学领域的疾病检测和治疗具有重要意义。

红细胞计数实验报告实验目的,通过本次实验,我们旨在了解红细胞计数的基本原理和方法,掌握红细胞计数的实验操作技能,以及掌握红细胞计数的结果分析和临床意义。
实验原理,红细胞计数是指在一定容积的血液中,红细胞的数量。
通过显微镜计数室和计数板,将血液稀释后装入计数板中,再在显微镜下进行计数。
通过计算出单位体积血液中红细胞的数量,从而得出红细胞计数值。
实验仪器和试剂,显微镜、计数板、横纹管、生理盐水、1%甲醇溶液、琼脂、血液标本。
实验步骤:1. 取一定量的横纹管,用生理盐水稀释血液标本,使红细胞适当稀释。
2. 在计数板中加入适量的稀释后的血液标本,使红细胞均匀分布在计数板的小格中。
3. 将计数板放入显微镜下,调节到适当倍数,用显微镜目镜直接观察。
4. 在显微镜下,选择计数板的一个小方格,计数红细胞的数量,根据标准计数板的格数和深度,计算出红细胞的数量。
5. 重复计数3-5个小方格,取平均值作为红细胞的计数值。
实验结果分析,根据实验数据,我们可以得出红细胞计数的结果。
通过比较正常值范围,可以判断出被检测者的红细胞计数是否正常。
红细胞计数值的异常与一些疾病有一定的关联,如贫血、失血、骨髓增生异常等。
实验注意事项:1. 实验操作要细致,避免气泡和污染。
2. 显微镜调节要准确,观察要仔细。
3. 稀释血液标本要均匀。
4. 计数板的清洁和消毒工作要做好。
实验总结,本次实验通过红细胞计数的操作,我们对红细胞计数的原理和方法有了更深入的了解。
同时,也掌握了红细胞计数的实验操作技能,以及红细胞计数结果的分析和临床意义。
通过本次实验,我们对红细胞计数有了更加全面的认识,为今后的学习和工作打下了良好的基础。
在实验中,我们也发现了一些问题,如实验操作中的细节问题、结果分析中的不足之处等,这些都需要我们在今后的学习和实践中加以改进和完善。
希望通过不断的学习和实践,我们能够更好地掌握红细胞计数的相关知识和技能,为将来的临床工作做好充分的准备。

红细胞的计数实验报告红细胞的计数实验报告引言:红细胞是人体血液中最常见的细胞成分之一,其数量的变化与人体健康状况息息相关。
本实验旨在通过计数红细胞的数量,了解血液中红细胞的浓度,并探讨红细胞计数实验的原理和方法。
一、实验原理红细胞计数实验是通过显微镜观察,利用计数室计数红细胞的数量来推算血液中红细胞的浓度。
在显微镜下,通过调整放大倍数和焦距,使红细胞清晰可见,并利用计数室的网格划分,计算红细胞的数量。
二、实验步骤1. 预备工作:a. 准备好显微镜和计数室,并确保其清洁无尘。
b. 用生理盐水将血液样本稀释,以便于计数。
c. 涂抹一层凡士林或甘油在计数室的盖玻片上,以增加视野的清晰度。
2. 准备显微镜:a. 将显微镜放在平整的台面上,调节光源和光强,确保光线均匀。
b. 将镜片放在显微镜的载物台上,并调整焦距,使红细胞清晰可见。
3. 开始计数:a. 将稀释好的血液样本滴在计数室的盖玻片上。
b. 将计数室盖玻片和载玻片合并,轻轻压紧,使血液均匀分布在计数室的网格中。
c. 在显微镜下,调整放大倍数和焦距,使红细胞清晰可见。
d. 选取一个网格,计数网格中的红细胞数量,并记录下来。
e. 移动到下一个网格,重复计数步骤,直至计数完所有网格。
f. 根据计数结果和计数室的网格大小,计算出红细胞的浓度。
三、实验结果在本次实验中,我们共计数了10个网格,得到的红细胞数量如下:网格1:75个网格2:68个网格3:70个网格4:72个网格5:74个网格6:69个网格7:71个网格8:73个网格9:76个网格10:75个通过计算,我们得到红细胞的平均数量为:(75+68+70+72+74+69+71+73+76+75)/10 = 71.3个。
根据计数室的网格大小,我们可以推算出红细胞的浓度为:71.3个/(1/4000 mm²)= 285200个/mm³。
四、实验讨论红细胞计数实验是一种常用的血液检测方法,它可以帮助医生评估患者的贫血程度、血液循环状况等。

红细胞计数实验报告红细胞计数实验是医学和生物学领域中的一个重要实验,它可以帮助我们了解血液循环系统的重要指标之一——红细胞计数。
本文将从实验步骤、原理、结果分析等方面对红细胞计数实验进行阐述。
实验步骤:1. 预处理:把要检测的血样取数,使用无菌针管把它放到另一个已有抗凝剂的试管中。
2. 制备计数板:我们需要选择计数板和盖片。
将盖片与计数板合并,间隙为0.1毫升。
盖板面向上,填充计数板的每一个小格,加入草酸铵洗涤液,静置十分钟,然后把草酸铵洗涤液倒出,计数板清洁干净。
3. 加样:重振样品,并加入计数板中,直到计数板中的每一个小格都充满血样。
轻轻移动计数板,让血样充分混合,然后等待三分钟。
4. 读数:将计数板装到显微镜中,用高倍镜(400倍或1000倍)观察并数红细胞。
读数时要特别注意,从左至右,从上至下的顺序清晰无误。
实验原理:红细胞计数实验的原理是利用显微镜配合计数板对血液中红细胞数量进行精确计量。
红细胞是人体内的血液成分之一,它们负责在人体内运输氧气,所以它们的数量也代表了血液中的氧气供应水平。
通过这个实验,我们可以准确地测定患者的血液中红细胞数量,帮助医生进行尽可能早的治疗。
结果分析:在实验中,我们可以通过显微镜观察计数板上的每一个小格子来得到红细胞的数量,然后通过统计每一列的红细胞数量来得到总数。
将这个总数除以计数板上的小格子数量和血样稀释后的倍数,就可以得到我们所需要的红细胞计数。
一般情况下,人类血液中红细胞数量在4.5-5.5百万/ 毫升之间,如果计算结果超出了这个范围,则说明患者存在可能的贫血症状。
总结:红细胞计数实验是一项精确而又常用的医学实验,它能够帮助我们了解血液中的红细胞数量,并在患者出现贫血等症状时第一时间进行治疗。
本文对红细胞计数实验的实验步骤、原理和结果分析进行了详细阐述,希望对读者在进行相关实验时能够起到一定的帮助。

红细胞计数一、实验目的:学习、掌握应用稀释法计数红细胞的方法二、实验原理:1.血液中血细胞数很多,直接计数有一定难度,需要将血液稀释到一定倍数,然后用血细胞计数板计数。
2.在显微镜下计数一定容积的稀释血液中的红细胞,之后需要将其换算成每升血液中所含的红细胞数。
三、实验用品:器具:显微镜、血细胞计数板、小试管、采血管、1mL和5mL移液管、玻璃棒、刺血针、干棉球试剂:哺乳动物红细胞稀释液、蒸馏水、75%酒精四、实验方法与步骤:1.采血2.稀释:用移液管取10微升血液,加至2mL红细胞稀释液中3.充池:将盖玻片的一边与计数池的纵线末端接触,然后缓慢放下,使盖玻片平放在计数室两侧的隆起上,醮少许红细胞稀释液靠近盖玻片乾元,靠毛细管作用将稀释液冲入计数池,于高倍镜下观察红细胞分布情况4.静置计数板2~3min 待经红细胞下沉后,大方格四角以及中央取5个4×4中方格红细胞数,用高倍镜或低倍镜计数5.计数,计算注意事项:1.保证计数板和盖玻片清洁;以防影响计数结果的准确性。
2.一次完成充池,如充池过少、过多、有气泡或出现任何碎片,应拭净计数板及盖玻片后重新操作。
3.充池后平放计数板,不能移动盖玻片。
4.计数板中细胞如果严重分布不均,应重新充池计数。
5.凡压线的细胞应按照数上不数下、数左不数右的原则,避免漏数或重复计数。
五、实验结果观察与记录以及分析:1.结果计算:(53+113+76+60+64)/5=73.2每16格平均73.2个红细胞,红细胞数:73.2×25×200×10×1000000=3.66×10的12次方个/升2.显微镜下图片①空白计数板:低倍镜:高倍镜:②400格:③16格(5个):16格计数图片:六、思考题:1.稀释液装入计数板后,为什么静置一段时间才开始计数?为使红细胞沉降完全2.显微镜载物台为什么应置于水平位,而不能倾斜?计数时是取某一视野内的细胞数来估算整体数的,如果倾斜了,会使一边多一边少,如果取了多的那边数个数,整体的就比实际值多了,取少的那边计算,整体就比实际值少了,误差太大。

红细胞计数实验报告
实验目的:
通过显微镜观察和计数方法,测定人体血液中红细胞的数目。
实验原理:
红细胞计数是指测定一定量血液中红细胞的数目。
它可以通过直接计数法和间接计数法来完成。
本实验采用的是直接计数法。
实验步骤如下:
1. 取一定量的血液样本,通常为1ml。
2. 将血液样本与一定体积的稀释液混合均匀。
稀释液一般为乌里森溶液。
3. 用显微镜调整放大倍数为400倍。
4. 在显微镜上放置红细胞计数板,使用可移动的网格计数器。
5. 用移动网格计数器逐个计数每一个网格内的红细胞数量,直到计数完所有的网格,记录下每个网格内的红细胞数目。
6. 根据计数结果计算平均数,并乘以稀释倍数,得到单位体积内红细胞的数目。
实验结果:
在显微镜下观察到的红细胞数目如下所示:
网格编号红细胞数目
1 130
2 125
3 140
4 135
5 128
6 132
实验数据处理:
根据实验结果计算平均值,即将每个网格内的红细胞数目相加后除以网格数目。
130 + 125 + 140 + 135 + 128 + 132 = 790
平均红细胞数目 = 790 / 6 = 131.67
由于我们对1ml血液进行了稀释,因此需要乘以稀释倍数才能得到实际的红细胞数目。
假设稀释倍数为100,则单位体积内红细胞数目为131.67 x 100 = 13167。
实验结论:
通过本实验的红细胞计数,得到单位体积内红细胞的数目为13167。
这个数值可以作为参考,用于评估人体的血液健康状况。
红细胞计数实验报告红细胞计数实验是生物学和医学领域常见的实验之一,通过对血液样本中的红细胞数量进行测定,可以了解人体内红细胞的健康状况和某些疾病的发展情况。
在本次实验中,我们使用了自动血球计数仪来完成红细胞计数实验。
实验的目的是通过计算单位体积内的红细胞个数,来了解受测样本中红细胞的浓度。
这个参数可以用来评估人体贫血程度,从而为临床诊断提供重要的参考依据。
首先,我们准备了所需的试剂和实验仪器,包括试管、自动血球计数仪、显微镜和荧光染料。
然后,收集了被试者的血液样本,确保样本的新鲜度和可靠性。
接下来,我们按照仪器的操作要求,将血液样本放入自动血球计数仪中进行测试。
在实验进行的过程中,我们需要注意一些细节。
首先,保持实验环境的清洁和无尘。
其次,在操作过程中要注意避免空气泡的产生。
空气泡的存在会影响实验结果的准确性。
此外,确保试剂的质量和有效期,以免影响实验结果。
通过自动血球计数仪,我们可以得到红细胞计数的结果,通常以每升血液中的红细胞数量表示。
根据国际标准,成年男性的正常红细胞计数范围为4.5-5.5 × 1012/L,而成年女性的正常范围为4.0-5.0 × 1012/L。
这个范围是根据大量的人群数据得出的统计结果。
实验结果显示,受测样本中的红细胞计数为5.2 × 1012/L,属于正常范围内。
这说明被试者的红细胞数量正常,没有贫血的情况。
红细胞计数的正常范围是维持人体正常机能所必需的,低于正常范围可能会导致贫血,而高于正常范围则可能与其他疾病的发生相关。
红细胞计数实验的结果还可以和其他相关指标一起进行分析。
例如,可以测定血红蛋白含量和红细胞压积,进一步评估红细胞的功能和生理状态。
这些指标综合分析可以更加全面地了解人体红细胞的健康状况。
尽管自动血球计数仪在实验中起到了重要的辅助作用,但需要注意的是,它仅仅是一个工具,实验结果还需要结合具体的临床病史和症状来进行综合分析。
实验诊断学实验报告红细胞计数试验实验目的:通过红细胞计数实验1、掌握红细胞计数方原理、方法及注意事项。
2、掌握血细胞计数板的结构试验器材:血细胞计数板、显微镜、盖玻片、试管、血红蛋白吸管、生理盐水实验原理:一定量的血液经一定量等渗性稀释液稀释后,充入血细胞计数池中显微镜下计数一定容积内的细胞,再换算成每升标本的细胞数报告。
操作步骤: 1、取红细胞稀释液2.0ml毫升,放入一小试管内。
2、用血红蛋白吸管吸血至l0ul处。
3、擦去管尖外部余血将血液迅速轻轻吹入盛有红细胞稀释液的试管内,上清液嗽洗吸管2-3次,立即摇匀。
4、将计数池与盖玻片用软布料擦净,将盖玻片覆盖于计数池上。
5、用吸管吸取混匀的红细胞悬液,充入计数池中。
6、待2—3分钟,让红细胞完全下沉后,将计数板平放在显微镜台上,用低倍镜观察,如红细胞分布均匀即可换高倍镜进行计数。
红细胞计数的区域:中心大方格中的5个中方格(正中一个和四角各一个)。
计数原则:数上不数下,数左不数右的计数原则即凡压在中方格边线(双线)上的红细胞,只计上侧与左侧线上的细胞,而压在下侧与右侧线上者不计入。
计算:红细胞数/l=5个中方格内红细胞数×5×10×201×106 或红细胞数/l=5个中方格内红细胞数÷100×1012 式中×5 5个中方格换算成1个大方格×10 1个大方格容积为0.1ul,换算成1.0 ul。
×201 血液的稀释倍数×106 由u1换算成l数据处理: rbc: ×l0/l12参考值男:(4~5.5)×10/l 12 女:(3.5~5)×10/l12 新生儿:(6~7)×10/l 12 答案不唯一,言之有理即可注意事项: 1、吸管、试管要注意清洁、干燥以防溶血,操作迅速避免血液凝固,如有血凝块应重新采血。
2充液前,红细胞复液要充分摇匀,红细胞悬液注入计数池内要求分布均匀,不可有气泡,亦不可有多余液体外溢。
红细胞计数的实验报告红细胞计数的实验报告引言:红细胞计数是一项常见的实验室检测项目,用于评估人体的健康状况。
本实验旨在通过显微镜观察和计数红细胞数量,了解红细胞的形态和数量对人体健康的重要性。
实验材料和方法:1. 材料:显微镜、血液样本、盖玻片、计数板、生理盐水、草酸铵溶液、染色剂(如甲苯胺染液)等。
2. 方法:a. 从被试者的手指或耳垂处采集一滴血液样本。
b. 将血液样本滴在盖玻片上,并与等量的草酸铵溶液混合。
c. 将盖玻片放在计数板上,用显微镜进行观察。
d. 在显微镜下使用高倍镜,随机选择一个区域进行红细胞计数。
e. 使用染色剂染色,以便更清晰地观察红细胞的形态。
f. 计算红细胞的数量,并记录实验结果。
实验结果:经过观察和计数,我们得出了以下实验结果:1. 红细胞形态:红细胞呈圆形或略呈椭圆形,直径约为7-8微米。
在染色剂的作用下,红细胞的细胞质呈现出淡红色,中央有一个凹陷的核。
2. 红细胞计数:在显微镜下,我们随机选择了10个视野进行计数。
每个视野中的红细胞数量分别为150、145、155、160、148、152、158、162、147和155个。
因此,平均红细胞计数为152个。
讨论:1. 红细胞形态与健康状况的关系:正常的红细胞形态是圆形或略呈椭圆形,这有利于红细胞在血管中的流动和氧气的运输。
如果红细胞形态异常,如出现溶血或贫血等病症,会影响红细胞的功能和数量。
2. 红细胞计数与健康状况的关系:正常成年人的红细胞计数范围通常为4.5-5.5×10^12/L,而儿童和孕妇的红细胞计数范围略高。
红细胞计数的偏高或偏低可以反映人体的健康状况。
例如,红细胞计数过低可能是贫血的表现,而红细胞计数过高可能是血液黏稠度增加的结果。
3. 实验误差和改进方法:本实验中,我们只选择了10个视野进行红细胞计数,这在一定程度上可能存在误差。
为了提高实验结果的准确性,可以增加视野数量,并进行多次实验取平均值。
实验报告红细胞计数实验报告:红细胞计数引言:红细胞计数是一项常见的实验技术,用于测量血液中红细胞的数量。
红细胞是血液中最常见的细胞类型,其主要功能是携带氧气和二氧化碳。
红细胞计数的准确性对于诊断和监测许多疾病具有重要意义。
本实验旨在介绍红细胞计数的原理、方法和结果解读。
一、实验原理:红细胞计数是通过显微镜观察和计数血液样本中的红细胞来完成的。
在显微镜下,红细胞呈现出典型的圆盘状形态,直径约为7-8微米。
通过统计显微镜视野中红细胞的数量,再结合血液稀释倍数,可以计算得到血液中红细胞的浓度。
二、实验方法:1. 准备血液样本:从被试者的指尖或静脉采集约1毫升的血液样本。
注意避免气泡的产生。
2. 稀释血液样本:将1滴血液样本滴入红细胞计数盘中的稀释液中,轻轻摇匀。
3. 装片:使用毛细玻璃管吸取稀释后的血液样本,将其滴在显微镜载玻片上。
避免过度稀释或过度浓缩。
4. 显微镜观察:将载玻片放在显微镜下,使用高倍镜进行观察。
在视野中选择一个代表性的区域进行计数。
5. 计数:在选定的区域内,使用显微镜计数眼镜或计数网格,记录红细胞的数量。
6. 结果计算:根据计数区域的面积、血液稀释倍数和计数得到的红细胞数量,可以计算出红细胞的浓度。
三、结果解读:红细胞计数的结果以每升血液中红细胞的数量来表示。
正常成年人的红细胞计数范围在4.0-5.5×10^12/L之间。
高于或低于这个范围的计数值可能意味着存在某种疾病或生理状态的异常。
1. 高红细胞计数:高红细胞计数可能是由于身体缺氧、高原适应、肺疾病、心脏病、肾脏疾病或骨髓异常等原因引起。
此外,长期使用某些药物、吸烟或饮酒过量也可能导致红细胞计数升高。
2. 低红细胞计数:低红细胞计数可能是由于贫血、失血、骨髓抑制、营养不良或免疫系统异常等原因引起。
某些药物的副作用、慢性疾病、感染或肿瘤也可能导致红细胞计数降低。
结论:红细胞计数是一项简单而重要的实验技术,可以提供有关血液健康状况的重要信息。
一、实验目的1. 了解红细胞计数的基本原理和方法。
2. 掌握使用显微镜和计数板进行红细胞计数的操作步骤。
3. 学会计算红细胞数量,并了解红细胞计数在临床医学中的意义。
二、实验原理红细胞计数是血液常规检查中的一项重要指标,通过计数一定体积血液中的红细胞数量,可以了解人体的血液状况。
本实验采用显微镜和改良Neubauer计数板进行红细胞计数,通过计算红细胞数量,得出每升血液中的红细胞数量。
三、实验器材与试剂1. 器材:显微镜、微量吸管、改良Neubauer计数板、载玻片、盖玻片、擦镜纸、生理盐水等。
2. 试剂:RBC稀释液(Hayem稀释液)、生理盐水或含1%甲醛的生理盐水。
四、实验步骤1. 标本制备:取外周血或抗凝血(EDTA抗凝)10μl,加入2.0ml RBC稀释液中,轻轻吹打混匀。
2. 充池:用微量吸管吸取混合好的血液,充入计数板计数室,静置3~5分钟。
3. 观察与计数:在显微镜下,用低倍镜找到计数室中央大方格,然后换用高倍镜依次计数中央大方格内4角和正中5个中方格内的红细胞数。
4. 计算红细胞数量:将计数室每个中方格容积为0.1μl,共计8个中方格中红细胞数乘以8,即为该体积内的红细胞数。
红细胞总数乘以稀释倍数(本实验为100倍)再乘以10^6,即为每升血液中的红细胞数量。
五、实验结果与分析1. 样液中红细胞的数量为:XX个2. 样液中白细胞的数量为:XX个通过实验,我们得到了样液中红细胞和白细胞的数量。
这些数据有助于了解人体的血液状况,为临床诊断提供依据。
六、注意事项1. 保证计数板、载玻片、盖玻片的清洁,以防影响实验结果的准确性。
2. 一次性完成充池,避免气泡和碎片的出现。
3. 压线的细胞,应遵循数上不数下,数左不数右的计数原则。
4. 血涂片制作要求厚薄均匀,注意涂片的量和时间。
七、实验总结本次实验通过使用显微镜和计数板,成功进行了红细胞计数。
通过实验,我们掌握了红细胞计数的基本原理和操作步骤,了解了红细胞计数在临床医学中的意义。
实验报告1(红细胞计数)
报告实验名称:红细胞计数实验内容:血液的采集;血液的稀释;红细胞计数实验目标:掌握红细胞计数的原理、方法及其临床意义实验方法、结果及讨论:
一、实验方法1、血液的采集。
2、稀释用5ml吸管吸取红细胞稀释液3、98ml置于试管中。
用沙利氏吸血管吸取全血样品至20μl刻度处。
擦去吸管外壁粘附的血液,将血液吹入试管底部,再吹、吸数次,以洗净沙利氏管内粘附的血细胞,然后试管颠倒混合数次。
3、冲液用毛细吸管吸取已稀释好的血液,放于计数室与盖玻片接触处,让血液稀释液自然流入计数室中静置1~
2min。
4、计数用低倍镜,光线要稍暗些,找到计数室的格后,把中央的大方格置于视野之中,然后转用高倍镜。
在中央大方格内选择四角与最中的五个中方格,每个中方格有16个小方格,所以共计数80个小方格。
计数时注意压在左边双线上的红细胞计在内,压在右边双线上的红细胞则不计数在内;同样,压在上线的计入,压在下线的不计入,此所谓“数左不数右,数上不数下”的计数法则。
二、实验结果每1升血液中的红细胞数=5个中方格内红细胞数/80400(小方格总数)200(稀释倍数)10(计数室深度)106=5个中方格内红细胞数1010=91012个/L
三、结果讨论送检鸡的红细胞数量相对性增多,可疑的疾病有腹泻、急性胃肠炎、渗出性胸膜炎与腹膜炎、热射病与日射病、某些发热性疾病及传染病等。
红细胞计数实验报告
红细胞计数实验报告
引言:
红细胞是人体内最常见的血细胞之一,它们携带氧气和二氧化碳,并在维持人体正常生理功能中发挥着重要作用。
红细胞计数实验是一种常用的临床检测方法,用于评估人体血液中红细胞的数量,从而判断贫血或其他疾病的存在。
本实验旨在通过显微镜观察和计数红细胞,探究红细胞计数的原理和应用。
材料与方法:
1. 血液样本:从健康志愿者的指尖或耳垂用无菌棉球轻轻擦拭,收集1-2滴血液。
2. 血液计数板:使用带有计数格的血液计数板,如Neubauer室。
3. 显微镜:使用高倍显微镜观察血液样本。
4. 盐水溶液:用于稀释血液样本。
实验步骤:
1. 取一滴血液样本,用盐水溶液稀释,使红细胞与盐水的比例适宜。
2. 将稀释后的血液样本滴入计数板的计数格中,注意不要过多或过少。
3. 将计数板放置在显微镜下,使用高倍镜观察计数格中的红细胞。
4. 计数格内的红细胞数量通常以5个小方格为单位进行计数,然后乘以适当的倍数,以获得每升血液中红细胞的数量。
结果与讨论:
通过实验观察和计数,我们得到了红细胞的数量。
根据正常参考值范围,我们可以判断出被检测者是否存在贫血等问题。
红细胞计数的结果可以作为诊断和
监测某些疾病的重要指标。
红细胞计数的原理是基于显微镜观察和计数。
计数格内的红细胞数量乘以相应的倍数,可以估算出每升血液中的红细胞数量。
这个倍数是由计数格的面积和深度确定的。
红细胞计数是临床常用的血液检测方法之一。
它可以帮助医生评估患者的贫血程度,判断贫血的原因以及监测治疗效果。
除了贫血,红细胞计数还可以用于其他疾病的诊断和监测,如肾脏疾病、心脏病和骨髓问题。
然而,红细胞计数也有一定的局限性。
在一些特殊情况下,如急性出血或急性感染,红细胞计数可能会出现异常结果。
此外,红细胞计数也无法提供红细胞的形态和功能信息,对于某些疾病的诊断可能需要其他血液检测方法的辅助。
结论:
红细胞计数实验是一种简单而有效的血液检测方法,用于评估红细胞数量和质量。
通过显微镜观察和计数,我们可以得到红细胞的数量,并根据正常参考值范围判断患者是否存在贫血等问题。
红细胞计数在临床诊断和监测中具有重要意义,但也需要结合其他血液检测方法来获取更全面的信息。